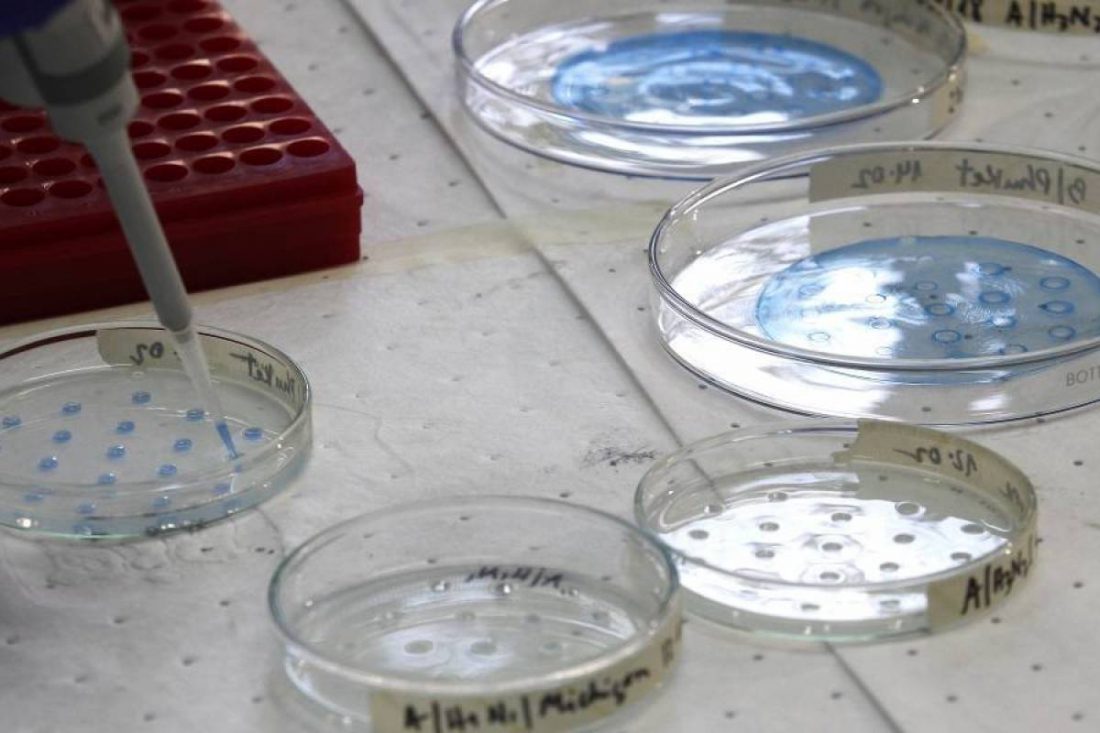
MUNDO: Medicamento contra acidez estomacal es probado como ...

El estudio comenzó hace unas semanas, pero los médicos de Northwell Health lo mantuvieron en secreto hasta ahora.
Lo que debes saber
- Mientras los investigadores compiten por desarrollar un tratamiento para Covid-19, un nuevo estudio ha producido resultados prometedores con un medicamento inusual
- Los médicos de Northwell Health desean saber si un medicamento común y económico para la acidez estomacal podría ofrecer un tratamiento para Covid-19
- El estudio comenzó hace unas semanas, pero los médicos de Northwell Health lo mantuvieron en secreto hasta ahora para garantizar que su arsenal de Pepcid fuera lo suficientemente grande como para llevar a cabo las pruebas
NUEVA YORK – Mientras los investigadores compiten por desarrollar un tratamiento para Covid-19, un nuevo estudio ha producido resultados prometedores con un medicamento inusual.
Los médicos de Northwell Health desean saber si un medicamento común y económico para la acidez estomacal podría ofrecer un tratamiento para Covid-19.
El estudio comenzó hace unas semanas, pero los médicos de Northwell Health lo mantuvieron en secreto hasta ahora para garantizar que su arsenal de Pepcid fuera lo suficientemente grande como para llevar a cabo las pruebas.
Los médicos de Northwell Health, en su sistema de 23 hospitales, están dirigiendo un ensayo para ver si el medicamento ayuda a los pacientes con Covid-19. Hasta el lunes, alrededor de 200 pacientes hospitalizados son parte del primer estudio de su tipo.
=> Recibir por Whatsapp las noticias destacadas
«Realmente tenemos que asegurarnos de que recibamos suficientes pacientes en este ensayo para que podamos responder a esa pregunta», dijo el Dr. David Battinelli, Director Médico de Northwell Health.
El ensayo comenzó a principios de este mes. La mitad de las personas recibirán famotidina (el nombre farmacológico de Pepcid) e hidroxicloroquina, mientras que los demás solo recibirán hidroxicolorquina.
Los investigadores dejaron de hablar sobre su trabajo durante semanas para que pudieran almacenar el medicamento antes de que otros hospitales e incluso el gobierno federal se volviera prudente y se apresurara a obtener el medicamento también. Los hallazgos iniciales de China son parte de la razón por la que piensan que esto puede funcionar. Los médicos observaron que los pacientes que tomaban el medicamento tenían una mejor tasa de supervivencia.
Los participantes del estudio obtienen nueve veces la dosis estándar del medicamento para acidez estomacal.
El personal de Northwell aún no está dispuesto a calificar el juicio como un éxito, pero lo que están viendo hasta ahora es prometedor.
Los resultados finales se esperan en unas cuatro semanas.
Fuente: telemundo47.com